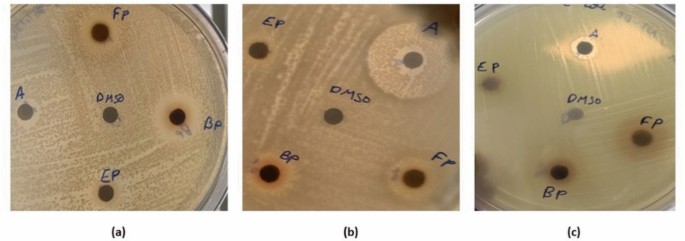
figure 4

Abstract
Rhodomyrtus tomentosa fruits, endemic to the Western Ghats were analyzed for its free, bound and esterified phenolics by Ultra High Performance Liquid Chromatography–Mass Spectrometry. Overall, twenty-nine phenolic compounds were identified, amongst them 18 were detected in this fruit for the first time. Gallic acid (80.44 ± 8.74 mg/100 g) and ellagic acid (107.47 ± 7.28 mg/100 g) were the most prominent ones found in the bound phenolic fraction and gallic acid (103.76 ± 6.34 mg/100 g) in the esterified phenolic fraction of the fruit, respectively. Total Phenolic content was found to be highest in bound phenolics (7.09 ± 0.17 mg Gallic acid equivalent/g). The antioxidant and antimicrobial activities of the three extracts namely free, bound and esterified phenolic fruit fractions have been analyzed. Bound phenolics exhibited the highest antioxidant potential (DPPH-15.63 ± 0.86; ABTS-34.73 ± 0.07; FRAP-17.89 ± 0.27 mg/g Ascorbic acid equivalent). The bound phenolics showed good antimicrobial activity against Bacillus cereus, Staphylococcus aureus and Escherichia coli with a MIC of 0.156, 0.625 and 1.25 mg/mL respectively. The exploration of phenolic compounds in Indian variety of Rhodomyrtus tomentosa fruits may provide useful insights on its utilization as a functional food ingredient.
Similar content being viewed by others
Introduction
The search for bioactive compounds in natural sources has increased in recent years. Wild edible fruits are natural resources with a potential to be exploited for its nutritional and nutraceutical properties. They may serve as a functional food ingredient to address various ailments namely cancer, diabetes, cardiovascular diseases, tumors and infections. Fruits tend to have various health benefits as they are enriched with several minerals, vitamins, and bioactive compounds like flavonoids, carotenoids, terpenoids, saponins, tannins, phenolic acids and steroids1. The biological activity or the health benefits are attributed to the combined and synergistic effect of phytochemicals present in them. Evidence prove that a single phytochemical compound cannot replace the biological activity of the whole fruit2. So, wild edible fruits are a treasure to be explored having wide applications in the food industry as functional ingredients or nutraceuticals. One such underutilized and unexplored fruits are the wild edible fruits of Rhodomyrtus tomentosa plant.
Rhodomyrtus tomentosa (Aiton) Hassk is an evergreen shrub extensively grown in Southeast Asian and South Asian countries. It is found in countries like China, Malaysia, Singapore, Vietnam, Philippines, Sulawesi, India and Srilanka. Rhodomyrtus tomentosa belongs to the family Myrtaceae. It grows in various soil and climatic conditions such as coastal areas, bog margins, natural forests, wetlands, riparian zones, and wet forests3. These shrubs are hardy, prefer natural daylight and are more resistant to pests and diseases. The common names given to this fruit are Rose myrtle, hill guava etc.4. The plant parts such as leaves, flowers, roots and buds have been an important part of Chinese, Vietnamese and Malaysian medicine. The unripe fruits have been traditionally used in Vietnamese medicine to treat diarrhea and the ripe fruits were consumed to boost immune system. This plant is considered to be a nourishing and effective medicine by the Chinese. The roots and leaves of this plant have been utilized to treat diarrhea and stomach aches in Indonesia. The components namely phenolic acids, flavonoids, triterpenoids, meroterpenoids and microelements have been reported among which piceatannol is found to be the major compound and Rhodomyrtone, a representative compound3,5.
The Southeast Asian variety of Rhodomyrtus tomentosa belonging to China, Philippines, Malaysia, Vietnam and Sulawesi have been studied extensively whereas, the variety endemic to Western Ghats, India is underutilized and yet to be explored6. The geographical location of plant species greatly influences the nature, therapeutic properties and composition of bioactive compounds7. A major difference between these two varieties is the color of the fruit. The Southeast Asian variety bears dark pink flowers with purple fruits whereas the Indian variety yields rosy white flowers with distinct greenish yellow fruits8. The Western Ghats is known to be one of the major biodiversity hotspots and a repository for medicinal plants9. Rhodomyrtus tomentosa is one of the unexplored and underutilized plants of this region. Rhodomyrtus tomentosa has been traditionally utilized by the tribal groups (Kotha, Kurumba, Kani and Kattunaiyaka) who inhabitate the Western Ghats. The people belonging to the kotha community utilize the flowers along with goat milk to treat diarrhea and the edible fruits are consumed. The kurumba tribal community utilizes the crushed leaves externally for tooth ache and inflammation. The Indian Rhodomyrtus tomentosa fruits are regionally known as thavittu pazham, thavittu koiya, thavittu pan etc. They are an important source of livelihood for tribal people. The edible fruits form a major portion of their food, medicines and constitutes an important source of income through sale. The unripe fruits are primarily used by the tribal communities for alleviation of gut health ailments. As of now, processing of the fruits is limited to the preparation of jam by the inhabitants of Nilgiris. Thus, there is a lot of potential to develop innovative food products for their optimal utilization. Studies on the Rhodomyrtus tomentosa endemic to the Western Ghat region in India has been hitherto restricted to the pharmacological activities of its leaves. It has been reported that the leaves of Indian variety of Rhodomyrtus tomentosa possesses gastroprotective, hepatoprotective, antioxidant and mosquitocidal properties10,11. There is lack of information on the nutritive or heath promoting compounds present in the fruits. The objective of this study is therefore to characterize the phenolic compounds present in the green Rhodomyrtus tomentosa fruits, followed by exploration of its antioxidant and antimicrobial potential.
With this background, the study on free, insoluble bound and esterified phenolics has been conducted using Ultra High Performance Liquid Chromatography–Mass Spectrometry (UHPLC-MS/MS) and bioactivities namely antioxidant and antimicrobial properties have been determined. Though there are studies on the fruits of Rhodomyrtus tomentosa, they are restricted to the Southeast Asian variety, our study stands out as it explores the edible green fruits native to India for the first time.
Materials and methods
Samples
This study complies with relevant national legislative guidelines. The ripened fruits were collected from The Nilgiris district of Tamil Nadu, India. The harvested fruits were cleaned to remove dust, dirt and extraneous matter. The washed fruits were freeze-dried (LSI Lyophilization Systems. INC. USA), pulverized and kept at − 20 °C for further analysis. The plant material was authenticated by Prof. K.N Amruthesh and the herbarium was deposited in Department of Studies in Botany, University of Mysore, Karnataka, India. The voucher specimen number UOMBOT23RT37 was assigned to the plant material.
Standards and reagents
MS-grade acetonitrile and methanol, gallic acid, ascorbic acid, ellagic acid, p-coumaric acid, piceatannol, sinapic acid, myricetin, catechin, quercetin, trolox, ferrous sulphate, ABTS, DPPH, TPTZ, resazurin, DMSO were obtained from Sigma Aldrich, USA. Muller Hinton Broth and Agar were purchased from Himedia. The remaining chemicals were analytical grade.
Extraction of phenolic fractions (free, bound and esterified phenolics).
The freeze-dried whole fruit powder was defatted using hexane and fractionated into free, insoluble bound and esterified phenolic12 as illustrated in Fig. 1. The defatted fruit powder (10 g) was subjected to extraction with 25 mL of 70% ethanol for three times. The phenolic fraction was centrifuged; supernatants were pooled and evaporated to remove ethanol. The leftover aqueous extract was acidified to pH 2.0 with 4N HCl. The free phenolics were separated using ethyl acetate by liquid–liquid extraction method. The ethyl acetate fraction was flash evaporated, followed by addition of 10 mL of MS Grade methanol for reconstitution. For the fractionation of esterified phenolics, the residual hydrolyzed product from the free phenolic fraction was treated with 2N NaOH (3 times) under nitrogen atmosphere for two hours. Further, 4N HCl was used to adjust the pH (2.0) of the extract, followed by extraction with ethyl acetate. The fraction of ethyl acetate was flash evaporated, followed by reconstitution with MS Grade methanol (10 mL). For the fractionation of bound phenolics, the residue after centrifugation from the free phenolic fraction was subjected to hydrolysis (3 times) using 2N NaOH for two hours under nitrogen atmosphere. Then, the pH of the product was adjusted to 2.0 using 4N HCl, followed by phase separation with ethyl acetate. The residual fraction of the bound phenolics was flash evaporated, followed by reconstitution similar to that of free phenolics. Free, bound and esterified phenolic fruit fractions were extracted and phenolic compounds analyzed using UHPLC-MS/MS.
Identification of phenolic compounds using UHPLC-MS
The Agilent 1290 Infinity II UHPLC-MS/MS system was used to identify the phenolic compounds present in all the three fractions. It contained a Triple-TOF LC/MS Mass Spectrometer (Sciex Triple ToF 5600+, Singapore). In addition, it was equipped with G7120A binary pump, G7167B multi-sampler and G7116B column compartment. The flow rate was set at 0.2 mL/min and the Kinetex C18 100A (30 × 2.1 mm 1.7 µm) was used for separation. The mobile phase A consisted of 0.1% formic acid in water and mobile phase B consists 0.1% formic acid in acetonitrile and methanol in the ratio 8:2. The gradient conditions used for the separation of the compounds is provided in the supplementary material (Supplementary table: S1). ESI negative mode was operated to acquire highly accurate mass measurements. The Duo spray ion source was operated at 400 °C with an Ion Spray Voltage Floating (ISVF) of 4500, the IRDx resolution was 28,287.602 and mass range from 100 to 1000 m/z was set. The column temperature was set to 35 °C. The Period Cycle Time was 1300 ms and the accumulation time was 250.0 ms. The gases used are Curtain Gas (CUR)-40, GS1-45 and GS2-60.
Peak View 2.1 Software (AB SCIEX Triple TOF 5600+, Singapore) was used for data interpretation and analysis. The TIC (Total Ion Chromatogram) of free, bound and esterified phenolic fractions was obtained through the Peak View software. The fragment ions were selected and extracted based on their quality (the highest quality was taken for further analysis) using the IDA explorer option in the PeakView software. Master view database present as a part of the software was used to identify the possible compounds from the NIST library, however only few compounds were identifiable using the library. The remaining extracted fragment ions and peaks from LC–MS were identified by comparing their molecular weight and the fragmentation pattern with PubChem database13 and published literature.
Quantification of phenolic compounds using UPLC-PDA
The ACQUITY UPLC- H Class with PDA system (MA, USA) was used to quantify the phenolic compounds present in the free, bound and esterified phenolic fruit fractions. The Syncronis C18 column (Thermoscientific) with 100 mm × 2.1 mm of diameter and particle size of 1.7 µm was used. Mobile Phase A (0.05% formic acid in water (H2O) v/v), Mobile Phase B (0.1% formic acid in acetonitrile v/v), wash solvent (80% methanol) and purge solvent (10% methanol) with a flow rate of 0.40 mL per minute and a run time of 15 min as per the gradient program listed in Supplementary table: S2 was used for quantifying the compounds.
The calibration curves of phenolic compounds such as gallic acid, ellagic acid, quercetin, myricetin, piceatannol, catechin, sinapic acid, and p-coumaric acid were obtained to determine the concentration of phenolic compounds in all the three phenolic extracts, respectively.
Assessment of total phenolic and flavonoid content
The total phenolic content of all three phenolic fruit fractions was assayed using Folin-Ciocalteu reagent and expressed in mg of gallic acid equivalent (GAE)/g of dry powder. Briefly, a sample volume of 400 μL was taken, and made up to 3 mL with distilled water. Then, 500 µL of Folin-Ciocalteu reagent was added, followed by the addition of 2 mL of 20% (w/v) Na2CO3, and incubation for 30 min under a dark condition12. The absorbance was measured at 765 nm with UV/VIS absorbance microplate reader (Clariostar, BMGLabtech) against a reagent blank.
The total flavonoid content was assayed using Aluminium Chloride method with slight modifications14. The crude extracts were diluted using methanol. Precisely, 200 µL of samples were taken and made up to 1 mL with methanol. Then, 1 mL of 2% (w/v) Al2Cl3 was added and the solution was incubated at room temperature for 15 min. The absorbance was read at 430 nm with UV/VIS absorbance microplate reader (Clariostar, BMGLabtech) against a reagent blank. The total flavonoid content was expressed in mg of quercetin equivalent (QE)/ g of dry powder.
Antioxidant property
1,1-diphenyl-2-picrylhydrazyl (DPPH) assay
The free radical scavenging activity was screened by DPPH method15 with slight modifications. The free, esterified and bound phenolic extracts were taken in different concentrations from 10 mL of extracts (dissolved in methanol) and made up to 3 mL with 0.004% DPPH in methanol. Then, solution was incubated under a dark condition at room temperature for 30 min. The absorbance was read at 517 nm against a blank with UV/VIS absorbance microplate reader (Clariostar, BMGLabtech). Ascorbic acid and Trolox were used as standards. The values were expressed in mg/g ascorbic acid equivalent (AAE) and trolox equivalent (TE).
Ferric reducing antioxidant power (FRAP) assay
Phenolic fractions were analyzed for their reducing capacity by the FRAP assay16. The FRAP reagent was prepared using 300 mM of acetate buffer (pH 3.6), 20 mmol/L FeCl36H2O, and 10 mmol/L TPTZ in 40 mmol/L HCl in the ratio of 10:1:1. Precisely, 100 µL of sample was taken and made up to 1 mL using FRAP reagent. The solution was incubated for 30 min at room temperature. The absorbance was measured at 595 nm with UV/VIS absorbance microplate reader (Clariostar, BMG Labtech) against a blank. The results were expressed in ferrous sulphate equivalent (FE) and ascorbic acid equivalent (AAE).
2,2’-azino-bis (3-ethylbenzothiazoline-6-sulphonic acid) diammonium salts (ABTS) assay
The free radical scavenging activity was screened using ABTS method described by15 with slight modifications. The ABTS stock was prepared by mixing 1:1 ratio of (v/v) of 2.6 mM potassium persulfate and 7 mM ABTS. The mixture was incubated overnight under a dark condition at room temperature. The ABTS working solution was prepared by mixing 1 mL ABTS with methanol in the ratio of 1:60 (v/v). The phenolic fractions were taken at different concentrations from 10 mL of extracts (dissolved in methanol) and made upto 3 mL with ABTS solution. The solution was incubated under a dark condition at room temperature for 6 min. The absorbance was read at 734 nm against a blank with UV/VIS absorbance microplate reader (Clariostar, BMG Labtech). Ascorbic acid and trolox were used as standards and the values were expressed in ascorbic acid equivalent (AAE) and trolox equivalent (TE).
Antimicrobial property
Antimicrobial sensitivity test by disc diffusion method
The antimicrobial sensitivity test of free, bound and esterified phenolics were done using disc diffusion method with slight modifications17. The test organisms used for the experiment were Staphylococcus aureus MTCC 1144, Bacillus cereus MTCC 1272 and Escherichia coli MTCC 1610. The bacterial suspension was adjusted to 0.5 McFarland standard (1.5 × 108 CFU/mL as final concentration) and inoculated into the Mueller Hinton agar (MHA) plates. The three fractions of phenolic extracts, ampicillin (positive control) and DMSO (negative control) were loaded into discs of 6 mm in diameter at appropriate concentrations. The loaded discs were placed on the inoculated MHA plates and incubated at 37 °C for 24 h. The zone of inhibition was noted.
Minimum inhibitory concentration (MIC)
Minimum Inhibitory Concentration of the three phenolics fractions was performed by the method described by17 with slight modifications. The extracts were taken at different concentrations (serially diluted from 10 to 0.019 mg/mL) in a 96 well plate along with Muller Hinton broth (50 μL) with a bacterial suspension (10 μL) adjusted to 0.5 McFarland standard (1.5 × 108 CFU/mL as final concentration). After a 24-h incubation, 0.02% resazurin dye (30 μL) was added and observed. The lowest concentration at which the wells remained blue in color was taken as the MIC.
Statistical analysis
All experiments were conducted in triplicates. Results were reported as mean ± standard deviation. Statistical analysis was performed using one-way ANOVA Duncan test as post-hoc and Pearson’s correlation coefficient using SPSS software.
Results
Identification of phenolic compounds using MS/MS fragments
The whole fruits of Rhodomyrtus tomentosa present in Indian region were analyzed for free, insoluble-bound and esterified phenolics. UHPLC-MS/MS led to the identification of 29 phytochemical compounds belonging to the classes of hydroxybenzoic acid, hydroxy cinnamic acid, methoxy cinnamic acid, flavonoid, flavonol glycoside, lignan, cyclohexane carboxylic acid, hydroxy cyclohexane carboxylic acid, alkyl phenol and other polyphenols. Total ion chromatogram and representative fragment peaks of phenolic compounds present in free, insoluble-bound and esterified phenolic fruit fractions is illustrated in Figs. 2 and 3. The phenolic compounds were identified by comparing its mass fragmentation patterns with the previously reported literature. The mass of parent ion (M-H) as well as the CID fragmentation were used for identification. Identified compounds are listed in Tables 1, 2 and 3.
In the whole fruits of Rhodomyrtus tomentosa grown in the Indian region, 21 free phenolic compounds, 16 insoluble-bound phenolic compounds, and 18 esterified phenolic compounds were identified. This is the first investigation reporting the phenolic profile of Rhodomyrtus tomentosa fruits endemic to the Western Ghats, India. All the three phenolic fruit fractions contained compounds such as quinic acid, gallic acid, pyrogallol, luteolin, piceatannol and 6-prenylnaringenin. The compounds namely myricetin, ellagic acid, quercetin and eriodictyol-7-O-glucoside were present in the free and bound phenolic fruit fractions. The free and esterified phenolic fruit fractions contained ethyl gallate, myricetin-3-O-galactoside and sinapic acid. Ferulic acid, catechin and chrysin were identified in both bound and esterified phenolic fruit fractions. Chlorogenic acid and 7-hydroxymatairesinol were seen only in free phenolics. Other phytochemical compounds such as p-coumaric acid and 4-vinylphenol were identified in the esterified phenolic fruit fractions. The phytochemical compounds like naringenin, quercetin, piceatannol, gallic acid, ferulic acid, and ellagic acid have been reported in the fruits of Southeast Asian variety as well5,18,19.
Hydroxybenzoic acids and its derivatives
Gallic acid, ellagic acid and ethyl gallate are the hydroxybenzoic acids identified in the Rhodomyrtus tomentosa phenolic fruit fractions.
The ESI–MS signal at m/z 169 was identified as gallic acid with the help of its major fragment ion m/z 125 which corresponds to the loss of CO2 molecule from the precursor ion (44 amu)20. Further confirmation was done by comparing the fragments ions with the fragmentation patterns available in the library.
Peak 9 with precursor m/z 301 (M-H) was present in free and bound phenolic fruit fractions at RT 10.4 and in esterified phenolics at RT 8.5. The precursor m/z 301 at RT 10.4 and 8.5 was identified and confirmed as free ellagic acid as it yielded daughter ions at m/z 257, 229 and 185 which were formed due to dissociation of the parent ion21. Hence, the compound was identified as ellagic acid.
The free and esterified phenolic fruit fractions showed a precursor at m/z 197, it produced major daughter ions at m/z 169 and m/z 125 which corresponds to the loss of C2H5 and CO2, respectively. The MS/MS fragmentation pattern of the precursor m/z 197 was compared with the reported literature and the compound was found to be ethyl gallate22.
Hydroxy cyclohexane carboxylic acid
A pseudomolecular ion was seen at m/z 191 in all the three phenolic fruit fractions. It produced fragment ions at m/z 101 (M-CO2-H2O-CO), m/z 111 (M-CO2-2H2O), m/z 129 (M-CO2-2H2O), m/z 155 (M-2H2O) and m/z 173 (M-H2O)23. These fragment ions are characteristics of quinic acid hence the peak 2 was identified as quinic acid.
Cinnamic acids and its derivatives
Hydroxycinnamic acids namely chlorogenic acid, ferulic acid and p-coumaric acid; methoxycinnamic acid such as sinapic acid were identified.
The parent ion m/z 193 was seen only in bound and esterified phenolic fruit fraction and yielded a daughter ion at m/z 134 resulting from the loss of a methyl group and a carboxyl group. According to reports, in a phenolic compound containing a methoxy moiety, a simultaneous loss of methyl group is accompanied by a loss in carboxyl group. Based on the fragmentation pattern, the precursor m/z 193 was identified as ferulic acid12.
A precursor m/z 163 was observed only in esterified phenolic fruit fraction which is assigned as peak 20. The major product ions produced were at m/z 119 and m/z 93. The product ion m/z 119 was produced due to a removal of CO2 (44 amu)24. By comparing the fragmentation pattern with previously reported data, peak 20 was assigned as p-coumaric acid.
In the free and esterified phenolic fruit fractions, peak 15 was seen with a precursor ion at m/z 223. A daughter ion was formed at m/z 179 as a result of loss of CO2 and the fragmentation pattern was similar to that of sinapic acid. So, the compound at peak 15 was designated as sinapic acid24 based on the fragmentation pattern and by matching the retention time of standard with that of the sample in UPLC-PDA results.
Flavonoids and flavonoid glycosides
Quercetin, myricetin, catechin, eriodictyol, naringenin, 6- prenylnaringenin, gallocatechin/epigallocatechin and luteolin were the flavonoids identified. Flavones namely chrysin, and eupatilin, flavonols such as quercetin, gallocatechin-3-O-gallate/ epigallocatechin-3-O-gallate and isorhamnetin, and flavonol glycosides like myrcetin-3-O-galactoside and eriodictyol-7-O-glucoside was identified in the phenolic fruit fractions of Rhodomyrtus tomentosa.
The precursor m/z 301(peak 11) at RT 12 was confirmed as quercetin due to the production of fragment ions m/z 151 and m/z 17925.
The esterified phenolics fraction exhibited a precursor at m/z 457 with fragment ions at m/z 125 and m/z 169 representing the decarboxylated gallic acid moiety and deprotonated gallic acid, respectively. These fragment ions lead to the identification of gallocatechin-3-O-gallate/epigallocatechin-3-O-gallate26.
The precusor m/z 305, present in the bound phenolic fraction at RT 18.219 was identified as gallocatechin/epigallocatechin by the formation of fragment ion at m/z 137 as a result of Retro-Diels Alder fragmentation reaction26.
The free phenolics fruit fraction showed a precursor at m/z 271 with the formation of fragment ions at m/z 93, m/z 119, m/z 107 and m/z 272 as a result of retro Diels–Alder reaction. The compound was designated as naringenin based on the fragmentation pattern reported previously27.
Peak 10 of both the free and bound phenolic fruit fractions revealed a precursor ion at m/z 317 with MS/MS base at m/z 151, m/z 179 and m/z 137. The fragment ion m/z 137 was formed due to Retro Diels–Alder reaction of flavon-3-ols with A ring (dihydroxylated), and B ring (trihydroxylated). In addition, the cleavage of heterocyclic C-ring produces the daughter ions m/z 151 and m/z 179. It is reported that these three fragment ions are characteristics of the compound myricetin, hence the precursor m/z 317 was designated as myricetin28.
Peak 22 with precursor ion m/z 289 was seen in bound and esterified phenolics. The product ions were formed at m/z 245, m/z 271 and m/z 125. Elimination of water molecule (18 Da) resulted in the formation of m/z 271, m/z 245 by loss of CH2=CH–OH (44 Da) and m/z 125 may have formed by heterocyclic ring fission elimination of A ring. The observed fragmentation pattern is a diagnostic feature of the compound catechin and peak 22 was identified as catechin29 based on the literature and by matching the retention time of standard with that of the sample in UPLC-PDA result.
Peak 7 found in free and esterified phenolic fruit fractions produced a deprotonated molecule at m/z 479 formed product ions at m/z 151, m/z 179, m/z 271, m/z 287, m/z 316 and m/z 317. The fragment ions m/z 317 and m/z 316 can be attributed to the loss of a hexose (162 Da) or deoxyhexose unit (146 Da) which is typical of a flavanol structure. The fragment ions m/z 151 and m/z 179 are typical product ions of myricetin. Further, a product ion at m/z 271 signifying the loss of C2H2O (46 Da) was seen. By comparing the above data with the reported fragmentation pattern30, the above compound was identified as myricetin-3-O-galactoside. This compound has been earlier reported only in the leaves of Myrtus communis which belongs to the same family.
The precursor m/z 285 was found in free phenolic fruit fractions. The precursor m/z 285 produced major daughter ions at m/z 133, m/z 151 and m/z 243 in free phenolic fruit fraction, whereas the major daughter ions seen in bound and esterified fruit fractions were m/z 241 and m/z 267. The fragment ions m/z 133 and m/z 151 were formed as a result of Retro-Diels Alder fragmentation. The fragment ions m/z 243, m/z 241 and m/z 267 were in agreement with the loss of C2H2O, CO2 and H2O molecules respectively. The comparison of fragment ions reported by31, led to the identification of peak 13 as luteolin.
Other compounds
Other polyphenols including stillbenoids, lignans, cyclohexane carboxylic acids and alkyl phenols were seen in the phenolic fruit fractions of the whole fruit.
The precursor m/z 243 with peak number 14 was present in all the three fractions. A fragment ion was generated at m/z 225 attributable to the removal of a H2O molecule which is caused by the presence of a catechol moiety 32,43. Other fragment ion such as m/z 199 was formed as a result of the loss of C2H2O. The major daughter ions were compared with previously reported literature5 and by matching the retention time of standard with that of the sample in UPLC-PDA results, the compound was detected as piceatannol.
Peak 4 exhibited a precursor ion at m/z 125 and major fragment ions were produced at m/z 107 and m/z 97 caused by loss of water molecule (18 Da) and CO (28 Da), respectively. So, this compound was confirmed as pyrogallol based on its fragmentation pattern33.
The esterified phenolic fruit fraction showed the presence of a precursor ion at m/z 119 and it yielded major daughter ions at m/z 91 and m/z 93. Based on the fragmentation pattern reported by Zhi and team34, it was detected as 4-vinylphenol.
Peak 23 was identified as 2-furoic acid which is an organic acid comprising a side-ring of carboxylic acid and furan. This compound exhibited a precursor ion at m/z 111 with daughter ions at m/z 67 indicating the loss of CO235 and was present in all the three phenolic fractions.
Among the 29 compounds which were identified using UHPLC-MS/MS, 18 compounds namely chlorogenic acid, pyrogallol, eriodictyol, eriodictyol-7-O-glucoside, myricetin-3-O-galactoside, luteolin, sinapic acid, 7-hydroxymatairesinoisol, 6-prenylnaringenin, chrysin, p-coumaric acid, 2-furoic acid, eupatilin, syringaldehyde, isorhamnetin, gallocatechin/epigallocatechin, gallocatechin-3-O-gallate/epigallocatechin-3-O-gallate and 4-vinylphenol are being presented for the first time in Rhodomyrtus tomentosa fruits. The mass error (ppm) was found to be higher i.e. > 20 ppm for compounds namely eriodictyol36, chrysin37, 6-prenylnaringenin38, eriodictyol-7-O-glucoside39, 7-hydroxymatairesinol40, dihydrocaffeic acid41,42, chlorogenic acid23, syringaldehyde35,41, eupatilin43,44, isorhamnetin45, luteolin31 (bound and esterified fractions), so these compounds were identified tentatively (Supplementary Tables: S5-S7). The compounds piceatannol, catechin and sinapic acid have been confirmed by UPLC-PDA identification and quantification though they showed a higher mass error (> 20 ppm). Moreover, piceatannol has also been reported in this plant, previously5. The compound isorhamnetin has been reported in the eugenia species belonging to the myrtaceae family46. The high mass error may be due to lower abundance of the analyte which in turn can lower the intensity of signals47.
Quantification of Individual phenolic compounds
The calibration curves of pure standards were obtained and used for the quantification of individual phenolic compounds using UPLC-PDA system. The compounds namely gallic acid, ellagic acid, myricetin, piceattanol, catechin, quercetin, p-coumaric acid and sinapic acid were present in quantifiable amounts (Table 4). The free phenolic fruit fraction contains the highest amount of ellagic acid, followed by gallic acid, myricetin and sinapic acid. The bound phenolic fruit fractions were seen to contain higher amounts of gallic acid followed by ellagic acid, quercetin, myricetin, catechin and piceattanol. The esterified phenolic fruits fractions consisted of higher amounts of gallic acid, followed by p-coumaric acid, catechin and piceattanol in trace amounts. Though sinapic acid was identified in the esterified phenolics fraction in UHPLC-MS/MS, it was not detected in UPLC-PDA as it was present in lower concentrations and the sensitivity of Mass Spectrometry is much higher that PDA detector.
Total phenolic content and total flavonoid content
Total phenolic content assay revealed that the bound phenolic fruit fraction was found to have more phenolic acids when compared to free and esterified phenolics (Supplementary table: S3). The free, bound and esterified phenolic content were found to be 5.22 ± 0.09, 7.09 ± 0.17 and 1.25 ± 0.01 mg GAE/g of dry weight respectively.
Total flavonoid content of free, bound and esterified phenolics was estimated as 2.71 ± 0.11, 2.64 ± 0.06 and 0.11 ± 0.00 mg quercetin equivalent/g of dry weight, respectively in the Indian variety of Rhodomyrtus tomentosa (Supplementary table: S3).
Antioxidant activities
Ascorbic acid, trolox along with ferrous sulphate were used as positive controls. In DPPH assay, bound phenolic (15.63 ± 0.86) fruit fraction exhibited the highest antioxidant potential followed by free phenolics (12.35 ± 0.15) and esterified phenolics (1.50 ± 0.01) expressed as mg/g Ascorbic acid equivalent (AAE). In FRAP antioxidant assay, bound phenolic (17.89 ± 0.27) fruit fraction showed the highest antioxidant activity in terms of mg/g Ascorbic acid equivalent followed by free (15.21 ± 0.11) and esterified phenolic (1.83 ± 0.06) fruit fractions. In ABTS antioxidant assay, bound phenolic (34.73 ± 0.07) fruit fraction exhibited the highest antioxidant activity followed by free (12.98 ± 0.14) and esterified phenolics (5.56 ± 0.12) in terms of Ascorbic acid equivalent. The bound phenolics from the Indian fruits showed higher antioxidant potential in DPPH, ABTS and FRAP assays, comparatively. In, addition, the antioxidant potential has been expressed in trolox equivalent. It showed a similar trend, bound phenolics was seen to have higher antioxidant potential.
Further, the antioxidant activity expressed in mg/g ascorbic acid, trolox and ferrous sulphate equivalent (Supplementary table: S3) were subjected to Pearson’s correlation coefficient test (Supplementary table: S4). Correlation between Total phenolic content, total flavonoid content and antioxidant activities was investigated by Pearson’s correlation coefficient test using SPSS software. The results showed a significant (p < 0.01) and positive correlation between total phenolic content (R2-0.992 AAE, R2-0.982 TE), Total Flavonoid content (R2-0.968 AAE, R2-0.981 TE) and DPPH antioxidant assay. A positive correlation was observed between total phenolic content (R2-0.987 AAE, R2-0.983 FE), total flavonoid content (R2-0.982 AAE, R2-0.986 FE) and FRAP antioxidant assay. The correlation between total phenolic content (R2-0.886 AAE, R2-0.901 TE) and ABTS antioxidant assay was found to be positive with a significance of p < 0.05. Whereas, the total flavonoid content (R2-0.678 AAE, R2-0.703 TE) and ABTS antioxidant assay showed a moderate correlation.
Antimicrobial activity
The antimicrobial property of free, insoluble-bound and esterified phenolic fruit fractions of the Indian variety of Rhodomyrtus tomentosa fruits were analyzed for the first time. The antimicrobial sensitivity test was done using disc diffusion method and the results (Fig. 4) proved that all three extracts showed a good inhibition zone against S. aureus in the order of bound phenolics (18.50 ± 0.71 mm) > free phenolics (16.25 ± 0.35 mm) > esterified phenolics (10.25 ± 0.35 mm) and B. cereus in the order of free phenolics (13.75 ± 0.35 mm) > bound phenolics (12.34 ± 0.53 mm)) > esterified phenolics (10.50 ± 0.71 mm) at a concentration of 10 mg/mL. The inhibition zone for E. coli was observed only for bound phenolics (8 ± 0.00 mm). The free and esterified phenolic fractions showed no inhibition against E. coli. The MIC test showed inhibition in the order of bound phenolics (0.156 mg/mL) > free phenolics (0.625 mg/mL) > esterified phenolics (1.25 mg/mL) against B. cereus. The inhibition of S. aureus was observed in the order of bound phenolics (0.625 mg/mL) > free phenolics (0.781 mg/mL) and esterified phenolics (0.781 mg/mL). The MIC test against E. coli showed that only bound fraction (1.25 mg/mL) was able to inhibit the bacteria; free and esterified fractions showed no inhibition against E. coli even at higher concentrations.
Discussion
This study investigates the free, bound and esterified phenolics present in the Indian variety of Rhodomyrtus tomentosa fruits and their bioactivity namely antioxidant and antimicrobial properties for the first time. The bound phenolics are the compounds which are bound to the structural compounds of cell-wall, covalently. They are released after a treatment with an alkali unlike free and esterified phenolics. The esterified phenolics are found to be conjugated to low molecular mass components and sugars. Both the free and esterified phenolics can be extracted using solvents such as water, acetone, ethanol and methanol48. So, the identification of free, bound and esterified phenolics plays an important role in assessing the biological activity of foods.
The phenolic acids present in the three phenolic fractions were identified by comparing the UHPLC-MS/MS fragments with available literature. In total, 29 compounds were identified in the Indian RT fruits among which 18 compounds were reported for the first time in this plant species. The phenolic acids present in Indian Rhodomyrtus tomentosa fruits were quantified using UPLC-PDA. By comparing the content of phenolic acids in the green Indian RT fruits and purple fruits of Southeast Asia dissimilarities in the phenolic contents were noted. For instance, gallic acid content in free and bound phenolics in purple variety of Rhodomyrtus tomentosa unmature fruits were found to be 7.02 mg and 71.72 mg /100 g respectively and 8.27 mg and 50.71 mg/100 g in mature fruits19. Using an optimized extraction method, Lai and co-workers49 reported the piceatannol content as 230 mg/100 g in the purple fruits but it was present only in trace amounts in the green fruits from the Indian region. These wide differences in the concentrations may be due to the variety, geographical location and the extraction techniques used. In the Indian variety fruits, gallic acid and ellagic acid were copiously present in the insoluble-bound and esterified phenolic fruit fractions when compared to purple fruits of Southeast Asia. Gallic acid is well established for its excellent anti-inflammatory, antimicrobial and gastro protective health benefits whereas, ellagic acid is known for its antioxidant, antimicrobial and antimutagenic properties. The tribal communities in the Western Ghat regions have been traditionally using Rhodomyrtus tomentosa fruits for the treatment of diarrhea, wound healing etc., which can be ascribed to the presence of phenolic compounds.
The total phenolic content and flavonoid content have been analyzed in all the three fractions and mentioned in Supplementary table: S3. A recent study by19 reported phenolic content (11.2 mg GAE/g) in free as well as bound fractions of the purple fruits. Higher total phenolic content ranging from 24 mg GAE/g50 to 49.2 mg GAE/g of dry weight51 has been reported previously for the purple fruits of Rhodomyrtus tomentosa. Hu19 and coworkers have reported flavonoid content of 5.3 and 3.1 mg rutin equivalent /g of dry weight, in free and bound fractions of the purple fruits respectively. The total flavonoid content of the fruits from Vietnam reported by Lai5 was found to be 1.52 mg quercetin equivalent/g of dry weight. Wu and co-workers have used a modified method for the extraction of flavonoids which yielded 62.09 mg rutin equivalent/g of dry weight18. Hitherto, the fruits of Indian variety have not been analyzed for their phenolic and flavonoid content.
The antioxidant activities of free, insoluble bound and esterified phenolics of the whole fruit were analyzed using ABTS, DPPH and FRAP assays. The phenolic compounds may exhibit antioxidant activity by various mechanisms namely as hydrogen donors, reducing agents, reactive oxygen species quenchers, reactive nitrogen species quenchers, transition metal chelators, oxidative stress inhibitors, enzyme inhibition and up-regulators of endogenous defense mechanism52. Hence, the antioxidant activities of the phenolic fruit fractions were estimated using three antioxidant assays such as ABTS, DPPH and FRAP to account for various antioxidant mechanisms.
The bound phenolic fraction exhibited highest antioxidant capacity in all the three antioxidant assays namely DPPH (15.63 ± 0.86 mg/g AAE), FRAP (17.89 ± 0.27 mg/g AAE) and ABTS (34.73 ± 0.07 mg/g AAE). The anthocyanin rich extract from the purple berries of Rhodomyrtus tomentosa showed 6.25 ± 0.25 µg/mL and 206 ± 2.37 μg/mL of IC50 value in DPPH and ABTS radical scavenging assays, respectively53. The antioxidant potential of the two varieties of Rhodomyrtus tomentosa fruits may be different due to their phytochemical composition which is evident in our study. The antioxidant capacity of phenolic fruit fractions depends on the type, concentration, structural configuration and mechanism of action of phenolic compounds present in them, leading to the difference in the scavenging activities of the phenolic fruit fractions in DPPH, ABTS and FRAP assays52.
Traditional use of Rhodomyrtus tomentosa fruits as an anti-diarrheal agent led us to the exploration of its antibacterial activity. Indian Rhodomyrtus tomentosa fruits possess a good antimicrobial potential and this bioactivity is being reported for the first time. Rosli54 has reported the antimicrobial property of the Southeast Asian variety fruits against S. aureus and E. coli with an inhibition zone of 16 mm and 12 mm but at unknown concentrations. In contrast, the Indian Rhodomyrtus tomentosa fruits showed good inhibition zones as shown in Fig. 4. The ethanolic extract of Jambolan fruit pulp showed an MIC of 2 mg/mL against E. coli and S. aureus, whereas the bound fraction of Indian Rhodomyrtus tomentosa fruits showed an MIC at 1.25 mg/mL and 0.625 mg/mL, respectively55. In addition, elderberry fruit extracts inhibited E. coli, S. aureus and B. cereus at an MIC of 7.81 mg/mL but Indian Rhodomyrtus tomentosa fruits showed a better MIC with 0.156 mg/mL against B. cereus56. In this study, the free and esterified phenolic fractions showed no inhibition and bound phenolic fraction showed a low inhibition against E. coli which may be attributed to the bacterial cell envelope. E. coli being a gram-negative bacterium, has three layers of cell envelope unlike the gram-positive bacteria which has a single layer of cell envelope, thus making the E. coli less vulnerable to certain phenolic compounds57. The antimicrobial potential of fruits can be attributed to the presence of phenolic compounds such as gallic acid, ellagic acid, luteolin, myricetin, quercetin and their combined effects58. The phenolic extracts from the ripe green Rhodomyrtus tomentosa fruits can be considered as potential antimicrobial agents for food and pharmacological applications. They can be incorporated directly into food or food packaging materials to prevent the growth of pathogenic microorganism, thereby ensuring a safe food for consumption. The notable difference in the phenolics and bioactivity of the Southeast Asian variety and Indian variety of fruits may be attributed to the color, geographical location, variety and the technique used for extraction.
Conclusion
The three phenolic extracts namely free, insoluble-bound and esterified phenolics were fractionated from the whole fruits of Rhodomyrtus tomentosa present in the Indian region, a novel source to be explored. UHPLC-MS/MS analyses demonstrated the presence of 29 phenolic compounds in this fruit, out of which 18 are being revealed for the first time. Comparatively, the bound phenolic fruit fraction contained the highest amount of phenolics, exhibited the highest antioxidant potential and antimicrobial activity. Gallic acid and ellagic acid having well established health benefits were prominently found in the insoluble-bound phenolic fruit fraction. Rhodomyrtus tomentosa has been traditionally used for various ailments by the tribal communities like the Kothas and Kurumbas for years and the phenolic profiling helps in providing a scientific basis to it. Though this fruit from the Western Ghats is unexplored and underexploited, it can be a promising functional ingredient in food products, thereby boosting tribal economy. It is envisaged that the identification and quantification of phenolic compounds will pave way for further characterization of its biological and pharmacological activities.
Data availability
All data generated or analysed during this study are included in this published article [and its supplementary information files].
References
Abcha, I. et al. Optimization of extraction parameters, characterization and assessment of bioactive properties of Ziziphus lotus fruit pulp for nutraceutical potential. Eur. Food. Res. Technol. 247, 2193–2209 (2021).
Egea, M. B. & Pereira-Netto, A. B. Bioactive compound-rich, virtually unknown, edible fruits from the Atlantic Rainforest: Changes in antioxidant activity and related bioactive compounds during ripening. Eur Food Res Technol. 245, 1081–1093 (2019).
Zhao, Z. et al. Rhodomyrtus tomentosa (Aiton.): A review of phytochemistry, pharmacology and industrial applications research progress. Food Chem. 309, 125715 (2020).
Hamid, H. A., Roziasyahira Mutazah, S. S. Z. & Yusoff, M. M. Rhodomyrtus tomentosa: A phytochemical and pharmacological review. Asian. J. Pharm. Clin. Res. 10, 10–16 (2017).
Lai, T. N. H. et al. Piceatannol, a potent bioactive stilbene, as major phenolic component in Rhodomyrtus tomentosa. Food. Chem. 138, 1421–1430 (2013).
Vattakaven, T. et al. India Biodiversity Portal: An integrated, interactive and participatory biodiversity informatics platform. Biodivers. Data J. 4, e10279. https://doi.org/10.3897/BDJ.4.e10279 (2016).
Quradha, M. M. et al. Comparative assessment of phenolic composition profile and biological activities of green extract and conventional extracts of Salvia sclarea. Sci. Rep. 14, 1885 (2024).
Johnson, J. & Lakshman, K. K. Ethnobotany of the kota tribes of the Nilgiris (Bharathiar University, Coimbatore, 1992).
Krishnan, P. N., Decruse, S. W. & Radha, R. K. Conservation of medicinal plants of Western Ghats, India and its sustainable utilization through in vitro technology. In Vitro Cell. Dev. Biol. Plant. 47, 110–122 (2011).
Geetha, K. M. & Sridhar, C. Phytochemical and pharmacological screening of some Indian medicinal plants for antioxidant and antiulcer property (Jawaharlal Nehru Technological University, 2011).
Kasinathan, M. & Elanchezhiyan, C. Mosquitocidal properties of solvent extracts and silver nanoparticles synthesized from Rhodomyrtus tomentosa (Aiton) Hassk. against three important human vector mosquitoes (diptera:culicidae). (Annamalai University, Chidambaram, 2019).
Prakash, O., Baskaran, R. & Kudachikar, V. B. Characterization, quantification of free, esterified and bound phenolics in Kainth (Pyrus pashia Buch.-Ham. Ex D.Don) fruit pulp by UPLC-ESI-HRMS/MS and evaluation of their antioxidant activity. Food Chem. 299, 125114 (2019).
Kim, S. et al. PubChem 2023 update. Nucleic Acids Res. 51, D1373–D1380 (2023).
Kumar, S. S., Manoj, P., Shetty, N. P. & Giridhar, P. Effect of different drying methods on chlorophyll, ascorbic acid and antioxidant compounds retention of leaves of Hibiscus sabdariffa L.. J. Sci. Food. Agric. 95, 1812–1820 (2015).
Rajesh, K. P., Manjunatha, H., Krishna, V. & Kumara Swamy, B. E. Potential in vitro antioxidant and protective effects of Mesua ferrea Linn. bark extracts on induced oxidative damage. Ind. Crops. Prod. 47, 186–198 (2013).
Veenashri, B. R. & Muralikrishna, G. In vitro anti-oxidant activity of xylo-oligosaccharides derived from cereal and millet brans - A comparative study. Food. Chem. 126, 1475–1481 (2011).
Sripahco, T., Khruengsai, S., Charoensup, R., Tovaranonte, J. & Pripdeevech, P. Chemical composition, antioxidant, and antimicrobial activity of Elsholtzia beddomei C. B. Clarke ex Hook f. essential oil. Sci. Rep. 12(1), 2225 (2022).
Wu, P. et al. Investigation of in vitro and in vivo antioxidant activities of flavonoids rich extract from the berries of Rhodomyrtus tomentosa (Ait.) Hassk. Food Chem. 173, 194–202 (2015).
Hu, X., Chen, Y., Dai, J., Yao, L. & Wang, L. Rhodomyrtus tomentosa fruits in two ripening stages: Chemical compositions, antioxidant capacity and digestive enzymes inhibitory activity. Antioxidants 11, 1390 (2022).
Medic, A., Jakopic, J., Hudina, M., Solar, A. & Veberic, R. Identification and quantification of the major phenolic constituents in Juglans regia L. peeled kernels and pellicles, using HPLC–MS/MS. Food Chem. 352, 129404 (2021).
Chen, H. et al. Antioxidant capacity and identification of the constituents of ethyl acetate fraction from Rhus verniciflua stokes by HPLC-MS. Nat. Prod. Res. 31, 1573–1577 (2017).
Li, J. et al. Comparative metabolism study on chlorogenic acid, cryptochlorogenic acid and neochlorogenic acid using UHPLC-Q-TOF MS coupled with network pharmacology. Chin. J. Nat. Medi. 19, 212–224 (2021).
Ramabulana, A. T., Steenkamp, P., Madala, N. & Dubery, I. A. Profiling of chlorogenic acids from bidens pilosa and differentiation of closely related positional isomers with the aid of UHPLC-QTOF-MS/MS-based in-source collision-induced dissociation. Metabolites 10, 178 (2020).
Yasir, M., Sultana, B. & Amicucci, M. Biological activities of phenolic compounds extracted from Amaranthaceae plants and their LC/ESI-MS/MS profiling. J. Funct. Foods. 26, 645–656 (2016).
Teixeira, L. D. L., Bertoldi, F. C., Lajolo, F. M. & Hassimotto, N. M. A. Identification of ellagitannins and flavonoids from eugenia brasilienses Lam. (Grumixama) by HPLC-ESI-MS/MS. J. Agric. Food Chem. 63, 5417–5427 (2015).
Singh, A., Kumar, S. & Kumar, B. LC-MS identification of proanthocyanidins in bark and fruit of six terminalia species. Nat. Prod. Commun. 13(5), 1934578X1801300511 (2018).
Wojakowska, A. et al. Structural analysis and profiling of phenolic secondary metabolites of Mexican lupine species using LC-MS techniques. Phytochemistry. 92, 71–86 (2013).
Rak, G., Fodor, P. & Abrankó, L. Three-step HPLC-ESI-MS/MS procedure for screening and identifying non-target flavonoid derivatives. Int. J. Mass. Spectrom. 290, 32–38 (2010).
Hamed, A. I. et al. Profiles analysis of proanthocyanidins in the argun nut (Medemia argun - An ancient Egyptian palm) by LC-ESI-MS/MS. J. Mass. Spectrom. 49, 306–315 (2014).
Pereira, P., Cebola, M. J., Oliveira, M. C. & Bernardo Gil, M. G. Antioxidant capacity and identification of bioactive compounds of Myrtus communis L. extract obtained by ultrasound-assisted extraction. J. Food Sci. Technol. 54, 4362–4369 (2017).
Fabre, N. et al. Determination of flavone, flavonol, and flavanone aglycones by negative ion liquid chromatography electrospray ion trap mass spectrometry. J. Am. Soc. Mass. Spectrum. 12, 707–715 (2001).
Stella, L. et al. Collisionally induced fragmentation of [M-H]- species of resveratrol and piceatannol investigated by deuterium labelling and accurate mass measurements. Rapid. Commun. Mass. Spectrom. 22, 3867–3872 (2008).
Ali, A., Cottrell, J. J. & Dunshea, F. R. LC-MS/MS characterization of phenolic metabolites and their antioxidant activities from australian native plants. Metabolites 12, 1016 (2022).
Chan, M. Z. A., Lau, H., Lim, S. Y., Li, S. F. Y. & Liu, S. Q. Untargeted LC-QTOF-MS/MS based metabolomics approach for revealing bioactive components in probiotic fermented coffee brews. Food Res. Int. 149, 110656 (2021).
Bortolami, M., Di Matteo, P., Rocco, D., Feroci, M. & Petrucci, R. Metabolic profile of Agropyron repens (L.) P. Beauv rhizome herbal tea by HPLC-PDA-ESI-MS/MS analysis. Molecules 27, 4962 (2022).
Dias, A. L. S. et al. Development and validation of an UHPLC-LTQ-Orbitrap MS method for non-anthocyanin flavonoids quantification in Euterpe oleracea juice. Anal. Bioanal. Chem. 405, 9235–9249 (2013).
He, L. et al. Rapid identification and quantitative analysis of the chemical constituents in Scutellaria indica L. by UHPLC-QTOF-MS and UHPLC-MS/MS. J. Pharm. Biomed. Anal. 117, 125–139 (2016).
Van Breemen, R. B. et al. Pharmacokinetic interactions of a hop dietary supplement with drug metabolism in perimenopausal and postmenopausal women. J. Agric. Food. Chem. 68, 5212–5220 (2020).
Geng, D., Chi, X., Dong, Q. & Hu, F. Antioxidants screening in Limonium aureum by optimized on-line HPLC-DPPH assay. Ind. Crops. Prod. 67, 492–497 (2015).
Zhu, Z. et al. LC-ESI-QTOF-MS/MS characterization and estimation of the antioxidant potential of phenolic compounds from different parts of the lotus (Nelumbo nucifera) seed and rhizome. ACS Omega 7, 14630–14642 (2022).
Frolov, A., Henning, A., Böttcher, C., Tissier, A. & Strack, D. An UPLC-MS/MS method for the simultaneous identification and quantitation of cell wall phenolics in Brassica napus seeds. J. Agric. Food. Chem. 61, 1219–1227 (2013).
Al-Rawahi, A. S. et al. Phenolic constituents of pomegranate peels (Punica granatum L.) cultivated in om. Eur. J. Med. Plants 4, 315–331 (2014).
Choi, Y., Jung, Y. & Kim, S. N. Identification of eupatilin from artemisia argyi as a selective PPARα agonist using affinity selection ultrafiltration LC-MS. Molecules 20, 13753–13763 (2015).
Tian, D. et al. Anti-inflammatory chemical constituents of: Flos Chrysanthemi Indici determined by UPLC-MS/MS integrated with network pharmacology. Food Funct. 11, 6340–6351 (2020).
Dubber, M. J., Sewram, V., Mshicileli, N., Shephard, G. S. & Kanfer, I. The simultaneous determination of selected flavonol glycosides and aglycones in Ginkgo biloba oral dosage forms by high-performance liquid chromatography-electrospray ionisation-mass spectrometry. J. Pharm. Biomed. Anal. 37, 723–731 (2005).
Maridass, M. & Ramesh, U. Chemosystematics evaluation of Eugenia species based on molecular marker tools of flavonoids constituents. Int. J. Biol. Tech. 1, 107–110 (2010).
Colby, J. M., Thoren, K. L. & Lynch, K. L. Optimization and validation of high-resolution mass spectrometry data analysis parameters. J. Anal. Toxicol. 41, 1–5 (2017).
Yu, M. et al. Comparison of free, esterified, and insoluble-bound phenolics and their bioactivities in three organs of lonicera japonica and l. Macranthoides. Molecules 24, 970 (2019).
Lai, T. N. H. et al. Optimisation of extraction of piceatannol from Rhodomyrtus tomentosa seeds using response surface methodology. Sep. Purif. Technol. 134, 139–146 (2014).
Huang, W. Y., Cai, Y. Z., Corke, H. & Sun, M. Survey of antioxidant capacity and nutritional quality of selected edible and medicinal fruit plants in Hong Kong. J. Food. Compost. Anal. 23, 510–517 (2010).
Lai, T. N. H. et al. Nutritional composition and antioxidant properties of the sim fruit (Rhodomyrtus tomentosa). Food Chem. 168, 410–416 (2015).
Arruda, H. S., Pereira, G. A., de Morais, D. R., Eberlin, M. N. & Pastore, G. M. Determination of free, esterified, glycosylated and insoluble-bound phenolics composition in the edible part of araticum fruit (Annona crassiflora Mart.) and its by-products by HPLC-ESI-MS/MS. Food Chem. 245, 738–749 (2018).
Cui, C. et al. Antioxidant capacity of anthocyanins from Rhodomyrtus tomentosa (Ait.) and identification of the major anthocyanins. Food Chem. 139, 1–8 (2013).
Rosli, M. F. A. et al. Phytochemical studies of Rhodomyrtus tomentosa leaves, stem and fruits as antimicrobial and antioxidant agents. Trans. Sci. Technol. 4, 396–401 (2017).
Singh, J. P. et al. In vitro antioxidant and antimicrobial properties of jambolan (Syzygium cumini) fruit polyphenols. LWT 65, 1025–1030 (2016).
Coman, M. M. et al. Polyphenol content and in vitro evaluation of antioxidant, antimicrobial and prebiotic properties of red fruit extracts. Eur. Food. Res. Technol. 244, 735–745 (2018).
Qian, M. et al. Inhibitory mechanisms of promising antimicrobials from plant byproducts: A review. Compr. Rev. Food Sci. Food Safe. 22, 2523–2590 (2023).
da Lima, M. C. et al. A review of the current evidence of fruit phenolic compounds as potential antimicrobials against pathogenic bacteria. Microb. Pathog. 130, 259–270 (2019).
Acknowledgements
Divya Priya A is indebted to University Grants Commission, New Delhi for award of Senior Research Fellowship.
Author information
Authors and Affiliations
Contributions
D.P.A. investigated, wrote the main manuscript text, methodology, and data analysis. A.M. conceptualized, supervised, provided resources, edited and reviewed. All authors reviewed the manuscript.
Corresponding author
Ethics declarations
Competing interests
The authors declare no competing interests.
Additional information
Publisher’s note
Springer Nature remains neutral with regard to jurisdictional claims in published maps and institutional affiliations.
Supplementary Information
Rights and permissions
Open Access This article is licensed under a Creative Commons Attribution-NonCommercial-NoDerivatives 4.0 International License, which permits any non-commercial use, sharing, distribution and reproduction in any medium or format, as long as you give appropriate credit to the original author(s) and the source, provide a link to the Creative Commons licence, and indicate if you modified the licensed material. You do not have permission under this licence to share adapted material derived from this article or parts of it. The images or other third party material in this article are included in the article’s Creative Commons licence, unless indicated otherwise in a credit line to the material. If material is not included in the article’s Creative Commons licence and your intended use is not permitted by statutory regulation or exceeds the permitted use, you will need to obtain permission directly from the copyright holder. To view a copy of this licence, visit http://creativecommons.org/licenses/by-nc-nd/4.0/.
About this article
Cite this article
Divya Priya, A., Martin, A. UHPLC-MS/MS based comprehensive phenolic profiling, antimicrobial and antioxidant activities of Indian Rhodomyrtus tomentosa fruits. Sci Rep 15, 945 (2025). https://doi.org/10.1038/s41598-024-84800-7
Received:
Accepted:
Published:
Version of record:
DOI: https://doi.org/10.1038/s41598-024-84800-7
Keywords
This article is cited by
-
Formulation of an instant multi-millet blend with enhanced antioxidant bioaccessibility
Journal of Food Measurement and Characterization (2026)
-
Piceatannol as a multi-target neuroprotective agent: mechanistic insights and therapeutic prospects in neurological disorders
Metabolic Brain Disease (2025)